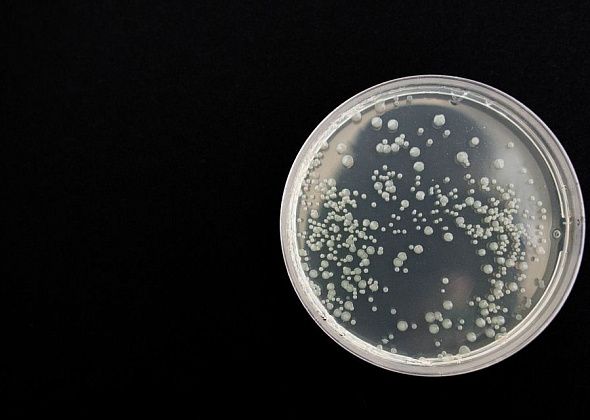
Роспотребнадзор: ситуация с острыми кишечными инфекциями в Карпинске крайне неблагополучная

Новости других городов
Карпинск
-20 °C
$80,72
€94,51